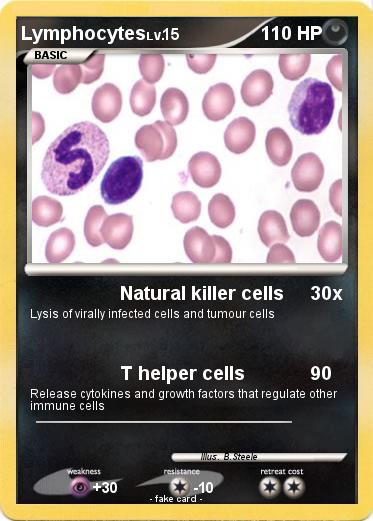
Pokemon Lymphocytes

Pokemon Lymphocytes 1
My card
Pokemon Passport
Creation Date : 5 March 2018
Name : Lymphocytes
Type : Darkness
Attack 1 : Natural killer cells
Lysis of virally infected cells and tumour cells
Attack 2 : T helper cells
Release cytokines and growth factors that regulate other immune cells
Illustrator : B.Steele
Related cards





MyPokeCard.com is a funny site to design your own pokemon card, vote for the best pokemon cards and create pokemon colorings